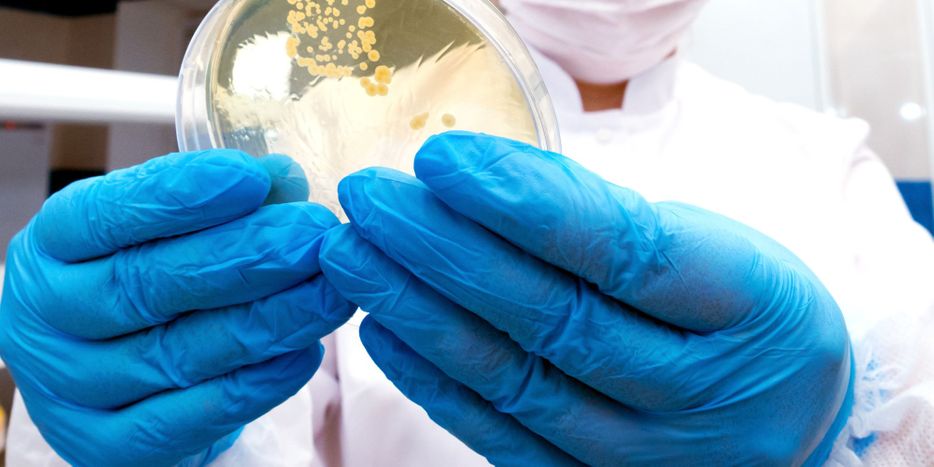

Car Maintenance Advice In COVID-19

Car maintenance is often overlooked, pay special attention to regular checkups and the overall maintenance of your car if you want to maximize the life and performance of your vehicle.
It is no secret that some parts of the car require more regular checking as compared to the others so it is mandatory to follow your vehicle’s maintenance schedule. The COVID-19 has further increased the demand for auto detailing because people often face car performance issues when it does not remain running and experiences low mileage.
Today in this article, we will cover why caring for your car is important.
Remember that it requires a little bit of effort but regular car maintenance will keep your car in top-running condition even in COVID-19.
The Importance Of Bacteria Removal
Learn how removing bacteria can greatly reduce the chances of sickness and infection.
Here are some tips on how to remove bacteria to keep your family safe.
A Definitive Guide To Auto Detailing For Beginners

If you own a car, then you are well aware of the term auto detailing. It is the act of cleaning the car in detail and involves thoroughly cleaning every crevice of an automobile.
In this article, we are intending on providing you with the detailed knowledge to carry out the car detailing process on your own. Remember that we are going to cover auto detailing techniques by consulting with the Austin Detailing service providers. This guide to auto detailing is for the exclusive exterior cleaning of the vehicles…
7 Benefits Of Window Tinting

All you need to know about your window tint purchase
Window tinting is a very beneficial option that is not limited to vehicles. You can also opt in for it for your home, boat, truck, commercial vehicle, or any other object with windows. Its popularity is increasing day by day due to its immense benefits such as safety, privacy, aesthetics,
However, the biggest benefit of window tinting is that it perfectly shields from the harmful UV rays of the sun. This is perhaps the primary reason why so many people choose window tinting for their homes, cars, and other structures with windows. Today, we will discuss the benefits of window tinting in detail that will help you in making an informed decision about whether or not you should opt for this option.
An Easy Guide To Window Tinting

The purpose of window tinting is pretty straightforward. When you are outside, you should keep yourself safe from harmful UV radiation, and if they are harming you when you are inside the car, you should opt for a window tinting service.
The interesting part?
People use it for protective purposes and add it to give the car a fabulous look. Window tinting can look very beautiful and attractive when done rightly. Thus, we can say there are various aspects of window tinting that make it something you should consider for your car. Today in this article, we will guide you through the process of window tinting and other relevant tips and instructions that will make it easy for you to decide whether or not you should opt in for it.
Let’s start from scratch and see what window tinting is.